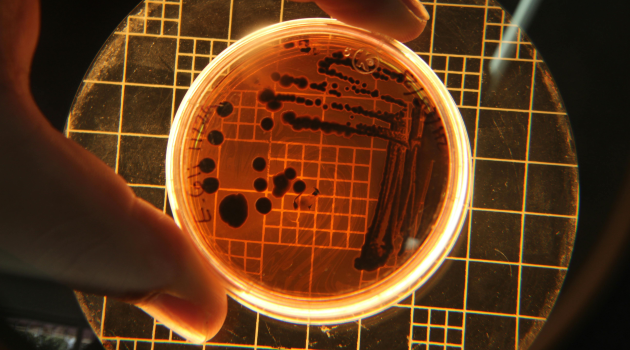

Miközben a technológia óriások egymás torkára lépve igyekeznek biztosítani maguknak a mesterséges intelligencia fejlesztéséhez és futtatásához szükséges erőforrásokat, a felhasználói oldalon egyelőre inkább csak kudarcokról és problémákról lehet beszámolni. Kivéve persze az olyan "rendkívüli sikertörténeteket", mint amilyennek a japán Studio Ghibli stílusát utánzó MI-képek bizonyultak pár napig az interneten. Azért szerencsére időről időre érkezik egy-egy olyan hír is, ami sokkal jobb képet fest a mesterséges intelligenciában rejlő valódi potenciálról.
A Stanford Egyetem tudósai nemrégiben publikált tanulmánya [PDF] szerint olyan vírusokat sikerült terveztetni egy speciális MI-modellel, amely hatékonyan pusztítota el a célpontnak kijelölt kólibaktériumokat. Az áttörésként értékelt eredmény eléréséhez egy jól megtervezett és összetett munkafolyamatra volt szükség.
A csapat első körben körülbelül 2 millió bakteriofág, azaz baktériumokat támadó vírus genomját tanította meg az Evo nevű modelnek. Ezt követően az algoritmust új genetikai szekvenciák megalkotására utasították a létező vírusok DNS-ének mintáiból építkezve. Az eredmény 302 mesterségesen előállított vírus lett, amelyek közül 16 működött is, azaz ezek a variácók elpusztították a labor Petri-csészéiben tenyésző E. coli baktériumokat.
Jókor jönne a segítség
Mindennek csak még nagyobb jelentőséget és aktuálitást ad a WHO héten megjelent jelentése, amelyben arra figyelmeztetnek, hogy a baktériumtörzsek egyre ellenállóbbnak mutatkoznak az ellenük kifejlesztett gyógyszerekkel szemben. Ma már ott tartunk, hogy globálisan minden hatodik bakteriális fertőzés rezisztenssé vált az antibiotikumokra.
Ráadásul a vírusok baktériumok elleni bevetése nem is ismeretlen az orvostudományban, a több mint egy évszázada felfedezett fágterápia pedig a rezisztenciaszint növekedése miatt egyre érdekesebb alternatívává válik. A remények szerint ezt a módszert teheti a mesterséges intelligencia a korábbihoz képest elképzelhetetlenül gyors, hatékony folyamattá.
Mindezek mellett azonban nem árt az óvatosság is. Nem véletlen, hogy a stanfordi csapat szándékosan nem "etette meg" a modellt emberi vírusok genomjával. Ahogy az egyik tudós fogalmazott: "Ha valaki ezt tenné a himlővel vagy az antraxszal, akkor komoly aggályaim lennének.”
Nyílt forráskód: valóban ingyenes, de használatának szigorú szabályai vannak